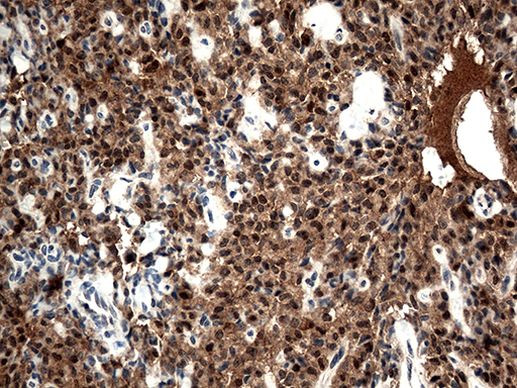
CSTB Antibody in Immunohistochemistry (Paraffin) (IHC (P))

Search
OriGene
CSTB Monoclonal Antibody (OTI5F2), TrueMAB™
{{$productOrderCtrl.translations['antibody.pdp.commerceCard.promotion.promotions']}}
{{$productOrderCtrl.translations['antibody.pdp.commerceCard.promotion.viewpromo']}}
{{$productOrderCtrl.translations['antibody.pdp.commerceCard.promotion.promocode']}}: {{promo.promoCode}} {{promo.promoTitle}} {{promo.promoDescription}}. {{$productOrderCtrl.translations['antibody.pdp.commerceCard.promotion.learnmore']}}
产品信息
TA813050
种属反应
宿主/亚型
分类
类型
克隆号
抗原
偶联物
形式
浓度
纯化类型
保存液
内含物
保存条件
运输条件
靶标信息
Cystatin A (also designated STF1, STFA, stefin A or cystatin AS) and cystatin B (also designated PME, CST6, STFB, CPI-B, stefin B and liver thiol proteinase inhibitor) are thiol protease inhibitors that form complexes with Papain and the cathepsins B, H and L. Cystatin A, a cytoplasmic protein, is one of the precursor proteins of the cornified cell envelope in keratinocytes and plays a role in epidermal development and maintenance. Cystatin B protects against intracellular proteases leaking out of lysosomes and is primarily expressed in heart, liver and kidney.
仅用于科研。不用于诊断过程。未经明确授权不得转售。
篇参考文献 (0)
生物信息学
蛋白别名: CPI-B; cystatin B (stefin B); Cystatin-B; Liver thiol proteinase inhibitor; stefin B; Stefin-B
基因别名: CPI-B; CST6; CSTB; EPM1; EPM1A; PME; STFB; ULD
UniProt ID: (Human) P04080
Entrez Gene ID: (Human) 1476